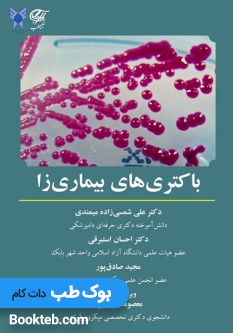

سیستینوزیس ( از تشخیص تا درمان )
بوک طب
سیستینوزیس ( از تشخیص تا درمان )
محصولات مشابه

Handbook of Wafer Bonding
520,000 تومان

شناخت طبایع – دوره طب سنتی و تغذیه دکتر ابواحبیب – جلد سوم
490,000 تومان

کتاب هاتا یوگا (تمرینات مقدماتی و پیشرفته) اثر سوامی ساتیاناندا ساراسوتی
558,000 تومان

Microservices for the Enterprise
510,000 تومان

3D Imaging in Endodontics
550,000 تومان

Precision Haematological Cancer Medicine
550,000 تومان

Modern Mainframe Development : COBOL Databases and Next-Generation Approaches
550,000 تومان

خرید و دانلود شبیه سازی مقاله اینورتر 3 فاز براساس مبدل cuk برای کاربردهای فتوولتاییک
511,000 تومان

نشریه شماره 110-2 مشخصات فنی عمومی و اجرایی تاسیسات برقی ساختمان جلد 2 دوم تاسیسات برقی جریان ضعیف (تجدید نظر دوم) آخرین ویرایش جدید - فروشگاه کتاب اشراق
533,600 تومان

خرید و دانلود نسخه کامل کتاب Essential Hydraulics - Book II: Fluid Power (Oil Hydraulic 2) - Pdf
497,000 تومان

Invasive Skull Base Mucormycosis دانلود کتاب الکترونیکی بهمراه فیلم ها
490,000 تومان

Basic Guide to Dental Radiography
550,000 تومان

Nuclear Medicine Therapy
550,000 تومان
باکتری های بیماری زا
499,500 تومان

The Perfectionists: How Precision Engineers Created the Modern World
500,000 تومان
کتاب کارخانه هوشمند تولید گیاه 4669
507,300 تومان

Characterization of Wide Bandgap Power Semiconductor Devices
560,000 تومان

معماری فرم فضا نظم - کتابفروشی کوچه کتاب
544,000 تومان

Statistics for Geography and Environmental Science
500,000 تومان

طرح توجیهی پرورش قارچ - Tarhtojihiorg
490,000 تومان
بررسی تغییرات قیمت
سیستینوزیس ( از تشخیص تا درمان )
Hello, world! This is a toast message.